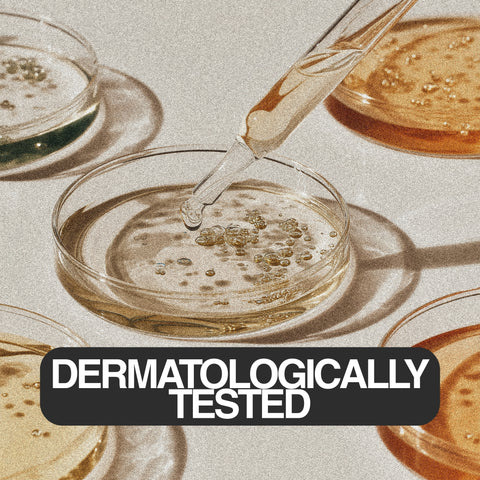

MORE INFORMATION:
INGREDIENTS/INCL:
STAR FEATURES:
CONCERN ADDRESSED:
SKIN TYPE:
AROMA: